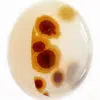
agate à inclusion

Agate à Inlcusions
63,05€ TTC
Agate à dendritique du Brésil
Très belle qualité choisi ! 100% Naturel
Original !!!
Ici nous avons un cabochon polie recto/verso . Sur une face avec un trés joli motif” floral” ou d’une fleur ou une empreinte de feuille!! ( chacun ca vision , son imagination). Jolie pièce unique de choix, pour collection ou pour la bijouteire , toujours bien contrastés et esthétiques!!!
Une belle œuvre d’art de la nature. Grosse pièce unique de collection .
Indispensable dans toute collection digne de ce nom ,faire un cadeau, un plaisir…
1 en stock
Informations complémentaires
| Poids | 28 g |
|---|---|
| Dimensions | 11 × 7 × 4 mm |
| Origine | Brésil |
| Poids | 20.95 carats |
| Forme | Cabochon, Ovale |
| Dimensions | 18 x 17 x 7.5 mm |
| Couleur | incolore, ( agate) , noir ( dendritique) |
| Clarté | Translucide |
| Traitement | aucun, pierre ornementale 100% naturelle |
| Dureté | 7/10 – Raye le verre – Pierres dures |
| Montage en bijou | Sans problème, avec les précautions d'usage. |
| Prix / cts | 3.01€ TTC |